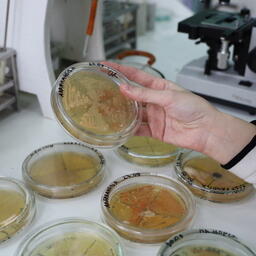
Ученые АГТУ получили новый вид бактерий для борьбы с нефтяными разливами. Фото пресс-центра учреждения

Для борьбы с нефтеразливами вывели новый вид бактерий
Ученые Астраханского государственного технического университета получили новый штамм микроорганизмов. Его планируется использовать для очистки Каспийского моря от нефтепродуктов и увеличения нефтеотдачи пластов.
Исследования проводились на кафедре «Прикладная биология и микробиология» АГТУ. Как рассказали Fishnews в пресс-центре университета, штаммы бактерий выделены из воды и донных отложений Каспийского моря в непосредственной близости от мест нефтедобычи. По данным мировой науки, именно аборигенные микроорганизмы максимально эффективны в разложении углеводородсодержащих соединений, отметили в учреждении.
Новые бактерии производят особые вещества — биосурфактанты, разбивающие нефтяную пленку на множество мелких капелек. Эта способность существенно ускоряет процесс биодеградации нефти, а также очень важна для повышения нефтеотдачи пластов, обратили внимание в АГТУ.
Работы ведут доктор биологических наук, профессор кафедры Ольга Сопрунова, кандидат биологических наук, доцент Алина Гальперина и студентка Алина Аларханова.
«Биотехнологические способы очистки от нефтяных углеводородов применяют наряду с химическими и физическими методами. Это позволит не только существенно снизить антропогенную нагрузку на экосистему Каспия, но и улучшить состояние природной среды. Применение микробных биопрепаратов при добыче нефти не вызывает изменений в составе нефти, не способствует коррозии труб и оборудования, а также снижает негативные последствия для окружающей среды», — рассказали авторы проекта.
Планируется, что полученные штаммы микроорганизмов станут основой для разработки новых биопрепаратов и могут быть широко использованы в добывающей отрасли на Каспии.
Отмечено: активная добыча и транспортировка нефти и судоходство сегодня сильно нагружают акваторию моря. В пресс-центре обращают внимание, что для вывода проекта на промышленный уровень необходима поддержка нефтедобывающих компаний. Их инвестиции позволят начать формирование совершенно новой отрасли промышленности в Астраханской области — биотехнологической, подчеркнули в АГТУ.
Больше новостей читайте в телеграм-канале Fishnews.
Fishnews





















